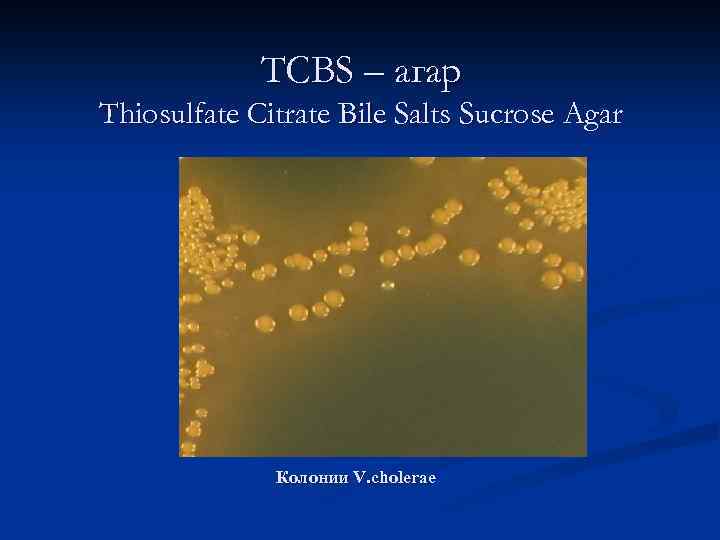
ТСВS – агар Thiosulfate Citrate Bile Salts Sucrose Agar Колонии V. cholerae

вибрионы 2.ppt
- Количество слайдов: 80

Патогенные вибрионы. Возбудители холеры, галофильные вибрионы Зав. кафедрой д. м. н. , профессор Г. И. Чубенко

Таксономия согласно таксономии Берги вибрионы входят в 5 группу- семейство Vibrionaceae. К семейству относят 5 родов. Медицинское значение имеют: роды: Vibrio, Aeromonas, Plesiomonas. .

Род Vibrio n n n прямые или изогнутые грамотрицательные палочки, не образующие спор; подвижны с помощью одного или многих полярно расположенных жгутиков; растут в аэробных и анаэробных условиях; продуцируют оксидазу (исключение V. metschnikovii); ферментируют глюкозу, некоторые с выделением газа.

Род Vibrio (34 вида) 1. Вид Vibrio cholerae 2. V. metschnikovii 9. V. nereis 3. V. arveyi 10. V. fluvialis 15. V. anguillarum 4. V. campbellii 11. V. furnissii 16. V. ordalii 5. V. para 1 haemolyticus 12. V. splendidus I 7. V. fischeri V. splendidus II 18. V. logei 6. V. alginolyticus 13. V. pelagius I 7. V. natriegens 19. V. pelagius II 8. V. vulnificus proteolyticus 14. V. nigripulchritudo 20. V. gazogenes 21. V. marinus 22. V. costicola 23. V. mimicus 24. V. damsela 25. V. hollisae 26. V. aestuarianus 27. V. diazotrophicus 28. V. orientalis 29. V. cincinnatiensis 30. V. salmonicida 31. V. tubiashi 32. V. mediterranei 33. V. carchariae

К патогенным вибрионам относятся возбудители холеры. Другие вибрионы - к условно-патогенным.

Возбудители холеры 1. Вид Vibrio cholerae а) биовары: V. cholerae asiaticae (классический) и V. cholerae eltor б) V. cholerae O 139

n На территории РФ в течении последних пяти лет имели место единичные завозные случаи холеры из республики Таджикистан, Индии, Китая.

V. cholerae открыл в 1854 году Пачини, он и дал название. n Роберт Кох изучил и дал полное описание свойств классического вибриона. n n В 1906 году Ф. Готлиб на карантинной станции Эль-Тор (Синайский полуостров) выделил второго возбудителя холеры вибриона Эль-Тор.

Особенности 7 пандемии n n n основной возбудитель - V. cholerae eltor (95 -99%); феномен айсберга: в 90% - атипичное, легкое течение значительный процент вибриононосительства: на каждый случай заболевания - 25 -100 вибрионосителей, отмечены случаи носительства до 3 - х лет; крайне высокая скорость распространения холеры формирование очагов вне Индостана; множественная лекарственная устойчивость V. eltor - практически действуют только нитрофурановые препараты

Морфология Вибрионы- изогнутая в виде запятой грамотрицательная палочка размерами 1, 5 -4, 0 х0, 2 мкм, монотрих- имеет полярный жгутик, снабжённый чехликом. Хорошо окрашивается анилиновыми красителями. Могут образовывать L-формы. Спор и капсул не образует.

Отличительной морфологической особенностью вибриона О 139 является наличие капсулы.



Антигенная структура Холерные вибрионы имеют два основных антигена: n 0 -антиген типоспецифический, термостабильный. n Н- жгутиковый, термолабильный

По структуpe 0 -Аг у вибрионов выделяют более 150 серогрупп. Возбудители классической холеры и холеры Эль-Тор входят в О 1 группу; 01 -антиген состоит из трех компонентов А, В, С, разные сочетания которых образуют серовары: Огава(АВ), Инаба (АС), Гикошима (АВС). Эти свойства используют в качестве эпидемиологического маркёра для дифференцирования очагов по возбудителям.

Подразделение V. cholerae по Оантигену О 1 О 2 non O 1 V. cholerae НАГ вибрионы О 3 О 4. . . О 138 О 139 Огава (ав) Инаба (ас) Гикошима (авс)

АГ структура n Н- антигены общие для большой группы бактерий, подразделяются на А и В группы; в группу А входят холерные вибрионы; в группу В вибрионы, биохимически отличные от холерных.

Резистентность Возбудители холеры способны к сапрофитному способу существования в водной среде. - При температуре 8°C размножение возбудителя холеры прекращается. - При температуре 5°C возбудители холеры могут сохранятся до 4 лет. -погибают при температуре 56°C - в течение 30 минут и мгновенно - при кипячении. - Высушивание и действие солнечных лучей губительны для вибриона (погибают через несколько часов). В условиях достаточно высокой влажности, вибрионы сохраняются в течение 2 -3 дней.

Вибрион особо чувствителен к воздействию кислот, даже в самых слабых концентрациях. n Дез. средства в невысоких концентрациях вызывают гибель холерных вибрионов в течение нескольких минут (хлорсодержащие препараты в концентрациях 0. 2 -0. 3 мг/л). n Губительно действуют на вибрион тетрациклин, нитрофураны. n

Биохимическая активность Факультативные анаэробы. Ферментируют многие углеводы: глюкозу, мальтозу, сахарозу и другие с образованием кислоты. Разжижают желатину, образуют индол, восстанавливают нитраты в нитриты, гидролизуют казеин. Обладают плазмокоагулирующим и фибринолитическим действиями

Воронкообразное разжижение желатины возбудителем холеры

Биохимическая активность n По способности ферментировать арабинозу, маннозу, сахарозу вибрионы патогенных видов распределены по разным группам Хейберга

Ферментативные группы вибрионов по Хейбергу и Бруа

Культивирование холерных вибрионов Необходима щелочная р. Н. Транспортные среды: n 1% пептонная вода с р. Н 8, 5± 0, 1 с теллуритом калия n 2% раствор поваренной соли

Среды обогащения для холерных вибрионов n 1% пептонная вода с р. Н 8, 4± 0, 2 n 1% пептонная вода с теллуритом калия (0, 1% раствор теллурита калия добавляют после стерилизации в конечном разведении 1: 100000 -1: 200000)

Элективные и дифференциальнодиагностические питательные среды СЭДХ n ТЦБС n ЩА n Монсура n

Культуральные свойства n n n Щелочной агар – круглые, гладкие, плоские, голубоватые, гомогенные с ровными краями, прозрачные в проходящем свете и светло-серые с голубоватым или зеленоватым оттенком в косом свете TSBS и СЭДХ – полупрозрачные, ярко желтые на зеленом или синем фоне среды Атипичные колонии: мутные с плотным центром, шероховатые, коричневые или желтые
ТСВS – агар Thiosulfate Citrate Bile Salts Sucrose Agar Колонии V. cholerae

Характер роста V. cholerae на полиуглеводных средах Среда Клигера Маннозосахарозная Дифференци- Характер роста рующие факторы Глюкоза (КГ) Лактоза Индикатор H 2 S Манноза Сахароза Индикатор H 2 S К--- К-+-

На жидких средах через 6 -8 часов образуют нежную тонкую поверхностную пленку, которая при длительном культивировании оседает на дно.

Факторы патогенности холерного вибриона n токсин-коpегулиpуемые пили адгезии – ген tcp на «остpове патогенности» хромосомы n Холеpный токсин (холероген) – гены ctx. AB (или vct. AB) в составе умеpенного нитевидного фага.

Экзотоксин- холероген- термолабильный белок. Инактивируется формалином. Состоит из 2 -х субъединиц А и В. Частица В (пять пептидов) определяет взаимодействие с эпителиальными клетками и Аг специфичность. Частица А- активирует внутриклеточную аденилатциклазу, приводит к повышению ц-АМФ и выходу электролитов и жидкости из клеток. n


Этиопатогенез Источник инфекции: больной или носитель Пути передачи: n Фекально-оральный n Водный n Контактно-бытовой Инкубационный период от нескольких часов до 5 дней.

Формы заболевания Типичные: желудочно-кишечные n Атипичные: молниеносная, сухая, стертая, бессимптомная, n Вибрионосительство n

Иммунитет Антимикробный, антитоксический n Относительно стойкий, видоспецифический С накоплением вибриоцидных АТ Ig. M и Ig. G. n Поствакцинальный иммунитет от 6 мес. до года.

4. 2 МЕТОДЫ КОНТРОЛЯ. БИОЛОГИЧЕСКИЕ И МИКРОБИОЛОГИЧЕСКИЕ ФАКТОРЫ Лабораторная диагностика холеры Методические указания МУ 4. 2. 1097 -02

Лабораторная диагностика 1 этап исследования. n Исследуемый материал засевают в 1% пептонную воду (первая среда накопления). n Параллельно материал от больных, исключая кровь, засевают на щелочной агар и одну из селективных сред. Посевы на плотных средах выращивают в термостате 16 -18 часов при температуре +37 С.

через 6 -8 часов от начала исследования делается пересев с пептонной воды на вторую среду обогащения, для чего материал из первой среды переносят петлей в 10 мл 1% пептонной воды и инкубируют при комнатной температуре. n Из первой пептонной воды делают высев на щелочной агар. n

Второй этап исследования. n Пересев материала со второй пептонной среды на щелочной агар и одну из селективных сред.


Третий этап исследования Изучают посевы со второй пептонной среды. Учитывают наличие роста в 1% пептонной воде без соли и элективных средах. Изучают морфологию клеток в мазках, окрашенных по Граму. Для дальнейшего исследования отбирают грамнегативные оксидазопозитивные культуры. n Засевают их на дифференциальнодиагностические среды (лактозо-сахарозную) для изучения видовых признаков

Микроскопия колоний в косопроходящем свете

Реакция иммобилизации вибрионов (РИВ) по МУ 4. 2. 1097 -02 2 капли испражнений, рвотных масс, верхнего слоя среды обогащения Сыворотка О 1 в разведении 1: 50 или О 139 – 1: 5 Фазово-контрастная или темнопольная микроскопия при увеличении х 400 -600 Время исследования – 15 -20 минут Чувствительность – 105 кл. /мл

Латекс-агглютинация с образцами жидкого стула + + - - J. J. FARMER III F. W. HICKMAN-BRENNER The Genera Vibrio and Photobacterium// Procariotae


Ускопенные методы диагностики Реакция иммобилизации n РИФ, n ПЦР, n РНГА n РН n

Исследования, выполняемые в лабораториях Рособрнадзора и ЛПУ, имеющих разрешение на работу с микроорганизмами III гр. патогенности n n Исследование материала от больных, контактных, из окружающей среды до установления отрицательного результата или выделения вибрионов. Идентификация вибрионов: мазок, оксидаза, рост на полиуглеводной среде, слайдагглютинация с холерными сыворотками О 1, Огава, Инаба, РО, О 139

Этиотропная терапия Антибиотики (тетрациклин, доксициклин), Антибиотик резерва- ципрофлоксацин n Симптоматическая терапия n

Химио-профилактики n Для экспресс профилактики у контактных людей применяют: n доксициклин внутрь по 0, 2 г 1 раз в сутки 4 дня; n рифампицин внутрь по 0, 3 г 2 раза в сутки 4 дня; n тетрациклин внутрь по 0, 5 г 2 раза в сутки 4 дня; n сульфатон внутрь по 0, 7 г 2 раза в сутки 4 дня; n левомицетин внутрь по 0, 5 2 раза в сутки 4 дня

Специфическая профилактика Вакцинация по эпидемическим показаниям. n Холероген-анатоксин n Химическая холерная вакцина n Корпускулярная убитая вакцина

Галофильные вибрионы Большой вклад в изоляцию и исследование галофильных вибрионов был внесен японскими исследователями Т. Фуджино и Р. Саказаки.

Галофильные вибрионы широко распространены в воде морей и океанов. Они обнаружены в морских гидробионтах (рыба, моллюски), водорослях, иле и соленой воде. Известно более 30 видов галофильных вибрионов, причем 17 из них способны вызывать заболевания у человека

Название вибриона Вызываемые заболевания V. parahaemolyticus V. аlginolyticus Гастроэнтериты, раневые инфекции и инфекции глаз Раневые инфекции, наружные отиты V. furnissii Гастроэнтериты V. hollisae Гастроэнтериты V. damsela Раневые инфекции V. vulnificus Септицемии или раневые инфекции, пневмонии, эндометриты V. fluvialis Гастроэнтериты, раневые инфекции

Морфология n n В мазках галофильные вибрионы имеют вид прямых или слегка изогнутых палочек с закругленными концами длиной до 1 -3 мкм, шириной 0, 2 -0, 4 мкм, лежащих хаотично отдельно друг от друга. характерен полиморфизм. Могут встречаться шаровидные формы, в некоторых случаях образуются нити. Спор и капсул галофильные вибрионы не образуют. Хорошо красятся анилиновыми красителями, грамотрицательны. подвижны благодаря наличию полярно расположенного жгутика.

Аг- свойства В настоящее время известно 12 типов О- и 64 типа К-АГ парагемолитических вибрионов, причем их сочетание стабильно. Наборы агглютинирующих О- и К-сывороток для серологического типирования выпускаются пока только в Японии.

Резистентность n обладают значительной устойчивостью к различным физическим и химическим факторам окружающей среды. Они сохраняют жизнеспособность при температуре +4 С в течение 2 -3 суток При комнатной температуре (+18 С, +20 С) галофилы способны выживать длительное время. При нагревании до +60 С, +80 С отдельные клетки галофильных вибрионов выживают в течение 15 минут.

Резистентны к бензилпенициллину, ампициллину, оксациллину, олеандомицину, ристомицину, неомицину, канамицину, сульфаниламидам, сульфаметаксозолу и триметоприму. Для дезинфекции используют препараты хлора, лизофин и лизоформин

Культуральные свойства Мезофилы, размножаются при t от +12, 8 С до +43 С (оптимальная температура +35 С, +37 С). Факультативные анаэробы, хорошо растут на питательных средах с обязательным содержанием Na. Cl от 0, 5% до 10%. (в жидких средах галофильные вибрионы растут при более высоких концентрациях Na. Cl). n концентрация водородных ионов (р. Н) - от 6, 0 до 10, 0 (оптимальная 7, 5 -8, 5).

n n На плотных средах образуют разнообразные по морфологии формы колоний и менее прозрачные. Характерен феномен роения. Для культивирования галофильных вибрионов используют питательные среды: Касаткиной, TСBS-агар, среды Эндо, Плоскирева, щелочной агар и пептонную воду с 3% Na. Cl.


n При росте в жидких средах образуется плотная, грубая пленка, но она вообще может отсутствовать.

Вирулентность адгезины, обуславливающие их выраженные адгезивные свойства, n фермент лецитиназа, n основной фактор патогенности термостабильный гемотоксин, определяет прямой гемолиз и термолабильный гемолизин n энтеротоксины и цитолизины n

n Представители многих видов обладают лизиндекарбоксилазой, обладают также ферментами индофенолоксидазами, диастазой, желатиназой, каталазой. У некоторых штаммов V. vulnificus описана способность к биолюминисценции.

характерный признак патогенных штаммов V. parahaemolyticus - способность к гемолизу эритроцитов кролика или человека на агаре, содержащем 7%Na. Cl. Этот тест получил название «феномена Канагава» . Штаммы, обладающие этим свойством, относятся к канагава-положительным, не обладающие – к канагава-отрицательным. n

Могут обладать антикомплементарной, (АКА), антилизоцимной (АЛА) и антиинтерфероновой активностью ( «АИА» )

Источником инфекции являются морепродукты не прошедшие надлежащей кулинарной обработки или инфицированные вибрионами после приготовления, в результате нарушения правил хранения и транспортировки готовой продукции, а также морская вода.

Кишечные заболевания Заболевания, вызываемые парагемолитическими вибрионами, могут протекать в виде трех клинических форм: n гастроэнтеритической (наиболее часто встречающейся), n дизентерие- и n холероподобной, при разной тяжести состояния.

Внекишечные заболевания n После ранений у иммунодефицитных людей и у наркоманов после инъекций могут развиться абсцессы на руках и ногах, причиной которых является заражение инъекционных ран и раневых участков морскими галофильными вибрионами. В этом участвуют V. alginolyticus, V. vulnificus, V. parahaemolyticus и др.

поражение по типу гангрены с последующим шоком, сосудистым тромбозом и смертью. n остеиты при травмах костей на воде, отиты и конъюнктивиты у пловцов. n реже реактивный артрит n

Лабораторная диагностика Бактериологическое исследование материала: испражнений, рвотных масс, промывных вод желудка; трупного материала (отрезки тонкого кишечника и желчный пузырь); в очаге эпидемической ситуации – пищевые продукты; из объектов окружающей среды – морская вода, ил, различные гидробионты, а также изготовленные из них пищевые продукты.

Критерии диагностики пищевых отравлений вызываемых V. parahaemolyticus «Критериями диагностики заболеваний вызванных V. parahaemolyticus является обнаружение их в подозреваемом продукте в количестве 106 и более живых клеток в 1 г/мл, с одновременным обнаружением того же типа возбудителя в кале пострадавших»

Посев материала (1 -2 дни исследования) согласно МУК 4. 2. 1793 -03 РВОТНЫЕ МАССЫ, ПРОМЫВНЫЕ ВОДЫ ЖЕЛУДКА, ИСПРАЖНЕНИЯ 1 -2 г (мл) ЩА (щелочной агар с 1, 5% Na. Cl) Элективные среды (СЭД), TCBS и др. 50 мл ПВ с 1, 5% Na. Cl 10 мл ПВ с 1, 5% Na. Cl ЩА ЩА

Посев материала (1 -2 дни исследования) согласно МУК 4. 2. 1793 -03 ОТДЕЛЯЕМОЕ РАН ПВ с 1, 5% Na. Cl Элективные среды (СЭД), TCBS и др. ПВ с 1, 5% Na. Cl ЩА ЩА

Кровяно - солевой агар (среда Wagatsuma) n n n n Дрожжевой экстракт - 5 г Пептон - 10 г Натрий хлористый - 70 г Маннит -5 г Агар - 15 г 0, 1% кристалл-виолет – 0, 01 мл Дистиллированная вода -1 л Растворяют все ингредиенты в воде, кипятят, устанавливают р. Н 7, 5. НЕ СТЕРИЛИЗУЮТ. Охлаждают до 50 о. С и добавляют 10% отмытых человеческих эритроцитов и разливают в чашки Среду инкубируют при 35 о. С 18 -20 часов. Энтеропатогенные V. parahaemolyticus вызывают гемолиз эритроцитов Инструкция. . . № 1135 -73

Штаммы дифференцируются по чувствительности к бактериофагам. Различают А, В, С и D монофаги, способные лизировать до 60% штаммов галофильных вибрионов, выделенных из разных экосистем.

Учитывают изменения в средах, засеянных в предыдущий день. По тестам идентификации определяют видовую принадлежность культур.

Лечение n n n восстановление нормального водно-солевого обмена или регидратация Этиотропная терапия показана при тяжелом и длительном течении заболевания- тетрациклин, препараты нитрофуранового ряда. При септических процессах и раневых инфекциях- карбенициллин, цефалотин, хлорамфеникол, гентамицин или тетрациклин

Профилактика неспецифическая- строгое соблюдение технологического и санитарногигиенического режима на предприятиях рыбной промышленности и общественного питания при переработке продуктов моря. Специфической профилактики нет.

Благодарим за внимание!
вибрионы 2.ppt